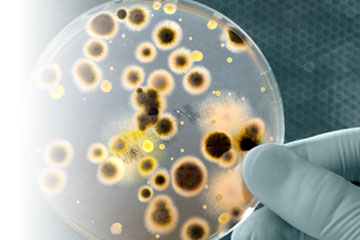

Case Studies
-
The First Forensic Scientists?

Forensic Enforcement - 28 February 2012
Glenn Taylor has collected memories and anecdotes from many practising and retired Public Analysts and produced a light read into forensic science outlining the history and their role. Over the last 150 years, the Public Analyst profession has hidden its light under a bushel and now it is time to tell their story with this collection of memoirs. Their accounts of samples submitted to them, how they analysed them, and the tales that unfolded, make for a fascinating insight into the field. See http://www.rsc.org/Shop/books/2010/9781847558718.asp for more details.
Read more -
The suspicious suitcase
Chemistry in Education - 01 May 2009
A gentleman entered an up-market, city centre hotel one evening pulling a suitcase, and tried to negotiate an acceptable price for a room for the night. Following much negotiation, he left reception and was caught on video camera in a number of locations within the hotel before abandoning the suitcase in the hotel bar.
Read more -
Environmental concern
Chemistry in Education - 01 May 2009
Over a period of at least seven years, a number of staff at a primary school had been diagnosed as having breast cancer. Staff were concerned that the environmental conditions contributed towards the disease. The public analyst laboratory was requested by environmental health and health protection to come up with a comprehensive survey to determine whether environmental conditions in and around the school were a contributing factor. A total of 118 samples were obtained and analysed during the course of this investigation.
Read more -
Nuisance odours

Chemistry in Education - 01 May 2009
Following repeated complaints of odours from a takeaway shop below a flat, the laboratory was requested to investigate. Using tenax tubes and air sampling pumps, an environmental health officer took samples of the atmosphere within the flat and sent them to the public analyst, who did a detailed analysis by gas chromatography using thermal desorption and mass spectrometry.
Read more